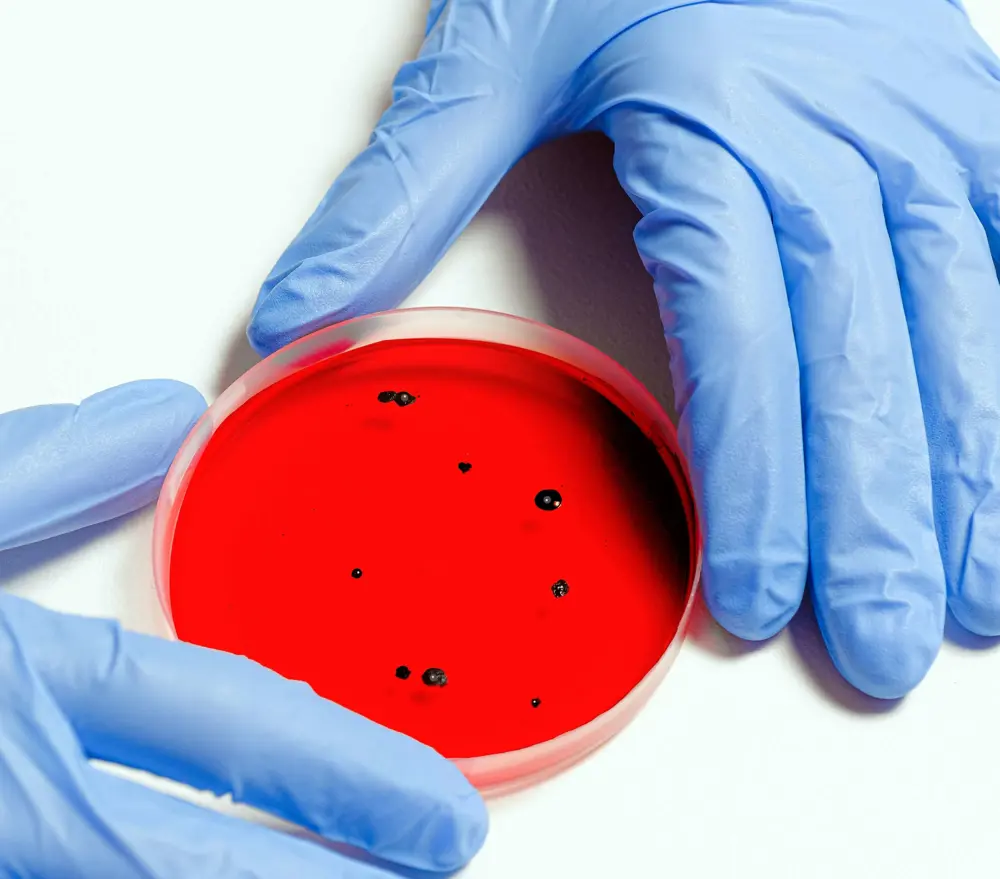
Yeni Bir Salgın mı Başladı?

Çok sayıda yabancı medyaya göre, tanımlanamayan ve tehlikeli bir bakteriyel enfeksiyon son zamanlarda Japonya'da hızla yayılıyor. Yeni bir salgın mı başladı? Günün sorusu…
“Toksik şok sendromu” (STSS) adı verilen bu hastalığa streptokok enfeksiyonu neden oluyor ve ölüm oranı yüzde 30’a kadar çıkıyor. Yalnızca bu yılın ilk iki ayında Japonya'da 378 vaka doğrulandı. Japonya Ulusal Bulaşıcı Hastalıklar Enstitüsü, bu bulaşıcı hastalığın neden bu kadar hızlı yayıldığının belirsiz olduğunu ve hastalığın arkasında hala birçok gizem bulunduğunu söyledi.
Geçen yıl Japonya'da 941 "streptokok toksik şok sendromu (STSS)" vakası bildirildi ve doğrulanan vakalar bu yılın Ocak ve Şubat aylarında doğrulandı. Hastalık şu anda Japonya'da şimdiye kadar kaydedilen en yüksek oranda yayılıyor ve klinik olarak hızla ilerleyen septik şok ve çoklu organ yetmezliği ile karakterize ediliyor. Sene başından itibaren veriler esas alınırsa, 2024 yılında enfekte kişi sayısının yeni bir rekor kırması ve geçen yılki rekoru önemli ölçüde aşması bekleniyor. Japonya'nın 47 ilinden sadece ikisinde bugüne kadar hiç vaka görülmedi.
Tıp camiası, streptokok enfeksiyonlarının neden olduğu septik şok sendromunun (STSS) hala yaygınlaştığı ve patojenin ölümcül doğası göz önüne alındığında özellikle endişe verici olduğu konusunda uyardı. Japonya Sağlık , Çalışma ve Refah Bakanlığı'na bağlı Ulusal Bulaşıcı Hastalıklar Enstitüsü (NIID), bu bulaşıcı hastalığın neden bu kadar hızlı yayıldığının henüz belli olmadığını söyledi.
Enstitüden bir yetkili, "Streptokoksik farenjitin ortaya çıkma mekanizması hakkında hala pek çok bilinmeyen nokta var, dolayısıyla bunu açıklayabilecek aşamada değiliz" dedi.
Yeni Bir Salgın mı Başladı? Japonya 1999'da ilk vakayı kaydetti!
Japonya bu hastalığı 1999 yılında kaydetmeye başladı. Japonya'nın resmi verilerine göre yaşlılar yüksek risk altında olsa da ölümlerin çoğu 50 yaş altı hastalardan kaynaklanıyor. Temmuz-Aralık 2023 arasında toplam 65 yaş altı hasta bulunuyor. 50'si enfekte oldu ve bunlardan 21'i öldü, yani üçte biri. Yaşlı yetişkinlerde soğuk algınlığına benzer semptomlar ortaya çıkabilir, ancak bazı durumlarda bu durum streptokokal farenjit, bademcik iltihabı, zatürre veya menenjite kadar kötüleşebilir. Ağır vakalarda organ yetmezliğine ve doku nekrozuna yol açabilir.
Geçen yıl Japonya'da STSS hastalarının sayısı önemli ölçüde arttı ve bazı uzmanlar bunun yeni koronavirüsün grip düzeyine düşmesi ve karantina tedbirlerinin gevşetilmesinden kaynaklandığına inanıyor. The Guardian da, toksik şok sendromu vakalarındaki önemli artışa dikkat çekerek bu endişe verici sağlık krizini haber yaptı.
Kaynak: Diyarbakır Söz